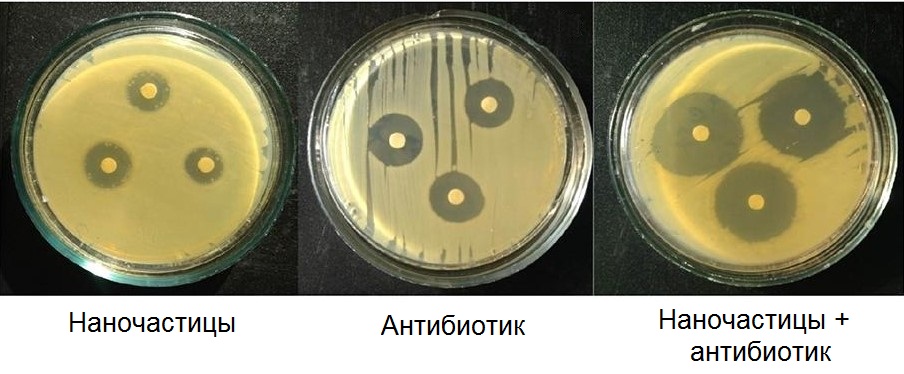

Исследование антибактериальной активности на образцах. Источник: пресс-служба ФИЦ «Красноярский научный центр СО РАН»
Антибактериальную активность полученных композитов ученые проверяли на золотистом стафилококке и кишечной палочке. Все композиты из наночастиц серебра с антибиотиком проявляли более высокую, чем у чистых лекарственных соединений, антибактериальную активность.
«Разработка антибактериальных препаратов с новой химической структурой сложна, дорогостояща и требует много времени. В то же время разработка новых комбинированных лекарств на основе известных антибиотиков может оказаться более эффективной, менее дорогостоящей и трудоемкой. Мы синтезировали композит наночастиц серебра в сочетании с различными цефалоспориновыми антибиотиками. Антибиотики цефалоспорины проявляют бактерицидное действие, подавляя активность бактериальных ферментов, препятствуя синтезу пептидогликанового слоя на стадии размножения и, тем самым, повреждая клеточную стенку бактерий. Наночастицы серебра, со своей стороны, оказывают губительное действие на мембрану, метаболизм и генетический аппарат бактерий. Таким образом, оба компонента комплекса оказывают повреждающее действие на клеточную стенку исследованных бактерий», — рассказал научный сотрудник Института химии и химической технологии СО РАН кандидат химических наук Сергей Александрович Воробьев.Работа выполнена при поддержке Российского научного фонда.

